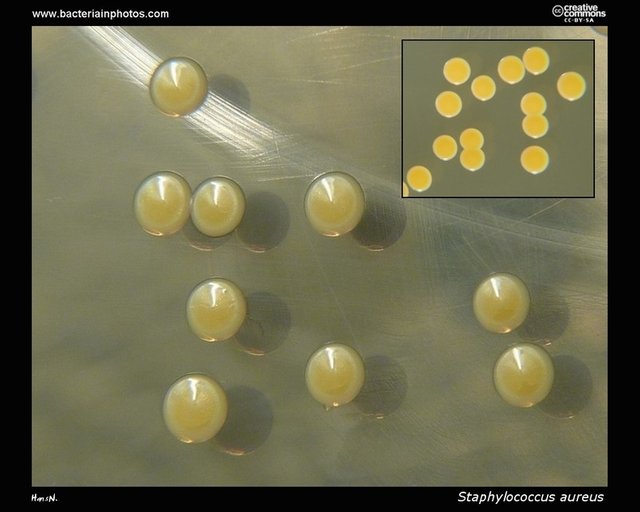

THE ISOLATION AND IDENTIFICATION OF STAPHYLOCOCCUS AUREUS FROM SKIN SAMPLES
INTRODUCTION
Bacteria are prokaryotes which consist of a single cell with a simple internal structure. They can live in the soil, in the ocean and inside the human gut. Humans’ relationship with bacteria is complex. Sometimes they lend a helping hand by curdling milk into yogurt, or helping with our digestion, other times they are destructive causing diseases like pneumonia.
Bacteria are very diverse and present everywhere such as in soil, water, sewage, standing water and even in human body. Bacteria that attack human body, is of great importance with reference to health. Transient bacteria are deposited on the skin surface from environmental sources and causes skin infections. Examples of such bacteria are Pseudomonas aeruginosa and Staphylococcus aureus.
Despite best labours to identify and eliminate infective microorganisms, they continue to emerge and re-emerge. These pathogenic bacteria significantly contribute to human illnesses and death especially as a result of hospice acquired infection/s.
Staphylococcus aureus is a gram negative, cocci bacterium that belongs to the family of the firmcutes and it is also commonly found on the skin or in the respiratory tract.
Staphylococcus aureus can be classified as a catalase positive organism therefore enabling it to convert hydrogen peroxide (H202) to water and oxygen. Essentially this unique feature can be used as a test to differentiate staphylococci and streptococci.
SCIENTIFIC CLASSIFICATION OF S.AUREUS
Domain Bacteria
Kingdom Eubacteria
Phylum Firmcutes
Class Coccus
Order Bacillates
Family Staphylococcaceae
Species S,aureus
Binomial nomenclature = Staphylococcus aureus
Staphylococcus aureus is positive for catalase and nitrate reduction, it is one of the most common cause of skin infections such as boils, respiratory disease such as sinutis and food poisoning
Initially Staphylococcus aureus was separated from other forms of staphylococci through the coagulase test. However, not all the strains of staphylococcus aureus are coagulase positive and that misdiagnosis of the wrong species can adversely influence proper treatment and control measures.
Staphylococcus aureus belongs to the family of firmicutes and can be easily found on the human respiratory tract and the skin. Though S. aureus may not always be pathogenic, It can be held responsible for common skin infections such as boils etc and respiratory disease eg sinusitis. The disease related strains often encourage by producing potent protein toxins, and expressing cell surface proteins which bind and inactivate antibodies.
The organism was first identified by a Scottish surgeon by the name of Sir Alexander Ogston in Aberdeen in the year 1880 from a surgical complication in a knee joint. Staphylococcus aureus was later theorized by Fredrich Julius Rosenbach who was credited by the official system of nomenclature.
However, an estimate showed that about 20% of the human population are carriers of Staphylococcus aureus and the organism can be found as part of the normal skin flora and in the frontal part of the nasal passages. Staphylococcus aureus is the most predominant specie of staphylococcus that can cause staph infections, and it is a thriving pathogen due to a combination of nasal carriage and bacterial immune-evasive strategies.
Staphylococcus aureus causes illnesses from minor skin infections such as folliculitis, carbuncles, cellulitis, scalded skin syndrome and life threatening diseases such as pneumonia, meningitis, osteomyelitis, endocarditis, toxic shock syndrome (TSS), bacteremia and sepsis.
The prevalence of Staphylococcus aureus varies from skin, soft tissue, respiratory, bone, joint, and endovascular to wound infection. Staphylococcus aureus can also cause post-surgical wound infections.
ROLE OF Staphylococcus aureus IN DISEASE
Staphylococcus aureus responsible for several infections, but it may also occur as a commensal (a form of association in which one organism derives benefit while the other neither benefits nor is harmed). Staphylococcus aureus can survive for a considerably long amount of time on dry, environmental surfaces depending on the strain.
Staphylococcus aureus can infect tissues when the mucosal barriers have been penetrated. However, Staphylococcus aureus infections can spread through contact from skin to skin with an infected person by releasing hyalaurondase which damages tissues and contact with objects such as towels, sheets, clothing etc.
image source:http://www.talkhealthpartnership.com/talkeczema/articles/images/Image
VIRULENCE FACTORS
The most relevant virulence factor of Staphylococcus aureus is the exact surface proteins which allow the organism to attach to host proteins. The surface proyein of this bacterium allow it to attach to host proteins such as laminin and fibronectin, which form the extracellular matrix of epithelial and endothelial cells.
Furthermore, Staphylococcus aureus produces some membranes destroying the toxins which allow the organism to further attack and damage the host of which the alpha toxin is the most premeditated and the toxin responsible for septic shock. However, alpha toxin is the protein that binds to a specific receptor inplatelets and monocytes in humans, forming pores which ends up destroying the cell.
EPIDERMIOLOGY
Staphylococcus aureus infection is one of the most widespread nosocomial infections due to wounds from surgery. Straphylococci are the most studied of the organisms residing on the skin due to their ubiquitous colonization of human skin and the wide spectrum of diseases they cause,
However, the dominant of the Staphylococcus species found on the skin is Staphylococcus epidermidis which is considered to be a general colonizer and part of a pan-micro biota. Furthermore, across different body regions, a substantial proportion of the skin community consists of coagulase-negative staphylococci including Staphylococcus hominis, Staphylococcus haemolyticus, Staphylococcus saprophyticus, Staphylococcus capitis, Staphylococcus warneri, Staphylococcus simulans and Staphylococcus cohnii.
Coagulase positive Staphylococcus aureus is not considered to be part of the natural skin normal flora of humans and nasal decolonization treatments reduce its frequency on skin while most coagulase negative staphylococci interactions with skin are likely commensal and they can cause a form of infection known as opportunistic infections
STAPHYLOCOCCUS AUREUS CELL WALL ASSOCIATED SURFACE PROTEINS
The ability of S. aureus to adhere to plasma and extracellular matrix (ECM) proteins deposited on biomaterials is a significant factor in the pathogenesis of device-associated infections. Several specific adhesins are expressed on the surface of S. aureus, which interact with a number of host proteins, such as fibronectin, fibrinogen, collagen, vitronectin and laminin, and have been designated MSCRAMMs (microbial surface components recognizing adhesive matrix molecules).
The biological importance of MSCRAMMs and their roles as virulence determinants are still being elucidated. To be classed as a MSCRAMM, the molecule of interest must be localised to the bacteria cell surface, and must recognise a macromolecule ligand found within the host’s ECM.
These ligands include molecules such as collagen and laminin, which are found exclusively in the ECM, and others such as fibrinogen and fibronectin, that are part-time ECM molecules but are also found in soluble forms such as blood plasma. The interaction of MSCRAMMs and the ECM should be of high affinity and specificity.
Numerous bacteria have been shown to bind a variety of ECM components, some of which have not been identified or characterised at the molecular level. A single MSCRAMM can bind several ECM ligands, whilst bacteria such as S. aureus can express several MSCRAMMs that recognise the same matrix molecule.
This type of variation and interactions resemble the ones between eukaryotic integrins and matrix molecules, in which the integrin can bind several different ligands, and one particular ligand may be recognised by several integrins. Many cell wall associated surface proteins of Grampositive bacteria can be identified by analysis of primary amino acid sequences.
At the N-terminal approximately 40 amino acids are required for Sec-dependent protein secretion, and the C-terminal contains a wall-spanning domain, rich in proline and glycine residues or composed of serine-aspartate dipeptide repeats, an leucine-proline- X-threonine-glycine (LPXTG) motif and a hydrophobic membrane-spanning domain followed by a series of positively charged residues.
The ligand binding functions are often located in the N-terminal domain. Most MSCRAMMs have an LPXTG motif, which is cleaved between the threonine and glycine by sortase.
In S. aureus, the carboxyl group of threonine is covalently bound to the carboxyl group of a pentaglycine sequence in the peptidoglycan. Hence, the N-terminal ligand binding domain is covalently linked to the cell wall peptidoglycan and can only be released from the cell wall by cleavage with the muralytic enzyme, lysostaphin.
Several proteins have been found to be covalently bound to the insoluble cell wall peptidoglycan in S. aureus via the sortase-catalysed pathway. Several in vitro studies have demonstrated that these adhesins (or MSCRAMMs) promote S. aureus attachment to each of the mentioned plasma or ECM proteins individually adsorbed onto polymer or metal surfaces.
Several proteins have been characterised biochemically and their genes sequenced, include protein A, fibrinogen binding protein, fibronectin binding protein, and collagen binding protein. There are many more such adhesins on the surface of S. aureus, which have yet to be identified and characterised.
S. AUREUS ASSOCIATED INFECTIONS
S. aureus is considered to be a major pathogen that colonises and infects both hospitalised patients with decreased immunity, and healthy immuno-competent people in the community. This bacterium is found naturally on the skin and in the nasopharynx of the human body.
It can cause local infections of the skin, nose, urethra, vagina and gastrointestinal tract, most of which are minor and not life threatening.
Over 4% of patients admitted into one of 96 hospitals in England between 1997 and 1999 for surgery acquired a nosocomial infection, which is defined as an infection where there was no evidence the infection was present or incubating prior to hospitalisation (Central Public Health Laboratory, UK, 2000).
The environment within a hospital also supports the acquisition of resistant S. aureus strains. The same study found 81% of the infections were caused by S. aureus, and 61% of these were methicillin resistant. The skin and mucous membrane are excellent barriers against local tissue invasion by S. aureus.
However, if either of these is breached due to trauma or surgery, S. aureus can enter the underlying tissue, creating its characteristic local abscess lesion, and if it reaches the lymphatic channels or blood can cause septicaemia.
The basic skin lesion caused by an S. aureus infection is a pyogenic abscess. However, S. aureus can also produce a range of extracellular toxins, such as enterotoxin A-E, toxic shock syndrome toxin- 1 (TSST-1) and exfoliative toxins A and B. Ingestion of enterotoxin produced by S. aureus in contaminated food can cause food poisoning.
TSST-1 is the toxin responsible for toxic shock syndrome (TSS) and is only caused by strains carrying the TSST-1 gene. TSS infections are commonly associated with menstruating women, particularly those using tampons. The exfoliative toxins are associated with staphylococcal scalded skin syndrome (SSSS).
SSS consists of three entities, toxic epidermal necrolysis, scarlatiniform erythema, and bullous impetigo, all of which damage the epidermal layer of the skin.
Once S. aureus attach to a surface, host cells are unable to dislodge them, demonstrated that teichoic acids on the S. aureus cell wall carry a negative charge, and have a key role in the first step of biofilm formation.
Biofilm formation is a two-step process that requires the adhesion of bacteria to a surface followed by cell-cell adhesion, forming multiple layers of the bacteria. Once a biofilm has formed, it can be very difficult to clinically treat because the bacteria in the interior of the biofilm are protected from antibiotics and phagocytosis.
Virulence factors such as proteases are produced once S. aureus has colonised a surface.
TREATMENT OF S. AUREUS INFECTIONS
The excessive use of antibiotics has led to the emergence of multiple drug resistant S. aureus strains. Penicillin was introduced for treating S. aureus infections in the 1940s, and effectively decreased morbidity and mortality. However, by the late 1940s, resistance due to the presence of penicillinase emerged.
The staphylococci are very capable of evolving resistance to the commonly used antimicrobial agents, such as, erythromycin, ampicillin, and tetracycline.
In most cases, resistance to antibiotics is coded for by genes carried on plasmids, accounting for the rapid spread of resistant bacteria. Soon after the introduction of methicillin, Jevons described the emergence of methicillin resistant S. aureus (MRSA), which have since spread worldwide as nosocomial pathogens.
However in 2002, the first vancomycin resistant S. aureus (VRSA) infection was documented in a patient in the United States. This strain was shown to carry a van gene, suggesting that the resistance determinant might have been acquired through the genetic exchange of material between vancomycin resistant enterococci and S. aureus.
The spread of vancomycin resistance worldwide is now inevitable, and could potentially result in a return to pre-antibiotic era. Hence, the identification of novel targets on the bacteria seems to be a pre-requisite in the search for new antibiotics and prophylaxis, e.g. vaccines.
MATERIALS AND METHOD
MATERIALS
The materials include conical flasks, test tubes, plastic petri dishes, inoculating loops, spirit lamp, incubator, digital weighing balance, test tube rack, cotton wool, nutrient agar medium, blood samples, sterile swabs, Mc Conkey agar medium, Mannitol salt agar medium, distilled water, masking tapes, refrigerator, hot air oven, autoclave, microscope, aluminum foil, Mc Cartney bottles and methylated spirit.
COLLECTION OF SAMPLES
The skin samples are obtained from people using peptone water, sterile swab sticks, methylated spirit and super absorbent cotton wool, under aseptic conditions.
STERILIZATION OF MATERIALS
Glasswares to be used are thoroughly washed and rinsed with distilled water, after which they are sterilized in the hot air oven at 160 C for 24 hours.
The inoculating loop and straight wire are flamed until red hot and then cooled before use.
Growth media are also sterilized in an autoclave at 121 C for 27 minutes.
PREPARATION OF MEDIA
All media are prepared according to the manufacturer’s instruction. In all experiments carried out, respective medium is weighed out accurately according to manufacturers’ instruction and dissolved in appropriate volume of distilled water. The resulting solution is then heated on the hot plate for homogeneity after which sterilization is done at 121 C for 27 minutes in an autoclave.
ISOLATION OF MICROORGANISMS
This is done by continuous culturing and sub-culturing using the spread plate technique by streaking the organism into the prepared media using the cotton swabs containing the organism under aseptic conditions.
SPREAD PLATE
The blood agar and Mac Conkey agar are dispensed into plastic petri dishes with the mouth of the conical flask being flamed after each dispensation to prevent possible microbial contamination.
The agar are allowed to solidify, streaked and then incubated for 24 hours. The plates are checked for growth and colonies are selected randomly based on the colour, shapes and surface appearance.
image source: http://www.sciencebuzz.org/sites/default/files/images/staphylococcus
PURE CULTURE
The selected colonies are sub-cultured on fresh Mc Conkey agar and Mannitol salt agar plates by streaking carefully on the medium using a sterile inoculating loop. The plates are incubated for 24 hours after which the plates are checked for growth. Apparent uniformity in growth as well as appearance of discrete colonies on the plate indicated a pure isolate.
image source:http://www.bacteriainphotos.com
GRAM STAINING AND BIOCHEMICAL TESTS
GRAM STAINING
Using a sterile wire loop, smears are prepared from the respective Mac Conkey agar plates and mannitol salt agar plates on sterilized glass slides.
Each of the slides are labeled to avoid mix up, a loopful of distilled water was placed on the slide. A colony of organisms is picked from the respective culture plate into the distilled water and is made into smear using a sterile wire loop.
It is air dried and heat fixed. Crystal violet stain is applied to the smear and allowed to stay for 1 minute. It was rinsed off the slide using water then it was stained with Lugos iodine for 1 minute and rinsed with the decolourizer after which the safranin was applied for 1 minute and rinsed.
The slides are examined microscopically under the X100 objective lens after a drop of immersion oil is applied on the surface of each slide and fitted with glass slide cover.
image source:http://www.bacteriainphotos.com
CATALASE TEST
Glass slides are cleaned with ethanol to remove grease after which a loopful of hydrogen peroxide is placed on the slide using a sterile inoculating loop. The slides are properly labeled too.
A colony of the organism is picked from the respective culture plates into the glass slides, and a drop hydrogen peroxide is added using a syringe. Oxygen bubbles are noticed.
OXIDASE TEST
Oxidase strips were placed on the work bench and colonies of the organism or inoculum were picked and smeared on the oxidase strips and observed for colour changes.
CITRATE UTILIZATION TEST
Koser’s citrate is prepared according to specification and sterilized at 121°C for 27 minutes. Agar slants using test tubes are prepared and allowed to solidify and the inoculum is introduced into each tube using a straight wire.
The organisms are inoculated into their respective bottles. The medium was incubated for 24 hours at 37°C. The organism which utilizes citrate changed the medium from blue to green.
COAGULASE TEST
Blood plasma is extracted using a sterile syringe and placed in drops into the inoculum which is smeared on a sterile glass slide.
The inoculum is then observed for whitish, cloudy colouration
REFERENCES
Ames GF, Nikaido, K (1976) Two-dimensional gel electrophoresis of membrane proteins. Biochemistry 15: 616-623.
Arens S, Schlegel U, Printzen G, Ziegler WJ, Perren SM, Hansis M (1996) Influence of materials for fixation implants on local infection. An experimental study of steel versus titanium DCP in rabbits. J Bone Joint Surg 78:647-651.
Baier RE, Meyer AE, Natiella JR, Natiella RR, Carter JM (1984) Surface properties determine bioadhesive outcomes: methods and results. J Biomed Mater Res 18: 337-355.
Boden MK, Flock JI (1989). Fibrinogen-binding protein clumping factor from Staphylococcus aureus. Infect Immun 57: 2358-2363.
Boxma H (1995) Wound Infections in Fracture Surgery. Thesis University of Amsterdam
Central Public Health Laboratory (2000) Surveillance of surgical site infection – in English hospitals 1997 1999.
UK.
Chang CC, Merritt K (1994) Infection at the site of implanted materials with and without preadhered bacteria. J Orthop Res 12: 526-531.
Cheung AL, Fischetti VA (1988) Variation in the expression of cell wall proteins of Staphylococcus aureus grown on solid and liquid media. Infect Immun 56: 1061-1065.
Cordero J, Munuera L, Folgueira MD (1994) Influence of metal implants on infection- An experimental study in rabbits. J Bone Joint Surg Br 76: 717-720.
Cramton SE, Gerke C, Schnell NF, Nichols WW, Gotz F (1999). The intercellular adhesion (ica) locus is present in Staphylococcus aureus and is required for biofilm formation.
Infect Immun 67: 5427-5433.
Deora R, Misra TK (1996) Characterization of the primary sigma factor of Staphylococcus aureus. J Biol Chem 271: 21828-21834.
Dickinson GM, Bisno AL (1989) Infections associated with indwelling devices: concepts of pathogenesis; infections associated with intravascular devices. Antimicrob Agents Chemother. 33: 597-601.
Eickhoff TC (1972) Therapy of staphylococcal infection. In: Cohen JO, ed. The Staphylococci. Wiley, New York. pp. 517-541.
Elek S (1956). Experimental staphylococcal infections in the skin of man. Ann NY Acad Sci 65: 85-90.
Foster TJ, O’Reilly M, Phonimdaeng P, Cooney J, Patel AH, Bramley AJ (1990) Genetic studies of virulence factors of Staphylococcus aureus- Properties of coagulase and gamma-toxin, alpha-toxin, beta-toxin and protein A in the pathogenesis of S. aureus infections. In: Novick RP, ed. Molecular Biology of Staphylococci. VCH Publishing, NewYork. pp 403-420.
François P, Vaudaux P, Foster TJ, Lew DP (1996) Hostbacteria interactions in foreign body infections. Infect Control & Hospital Epidem 17: 514-520.
Gerber HW, Perren SM (1980) Evaluation of tissue compatibility of in vitro cultures of embryonic bone. In: Winter GD, Leray JL, De Groot K, eds. Evaluation of Biomaterials. Wiley, Chichester, UK. pp 307-314.
GiraudoAT, Raspanti CG, Calzolari A, Nagel R (1994) Characterization of a Tn551-mutant of Staphylococcus aureus defective in the production of several exoproteins. Can J Microbiol 40: 677-681.
GiraudoAT, Calzolari A, Cataldi AA, Bogni C, Nagel R (1999) The sae locus of Staphylococcus aureus encodes a two-component regulatory system. FEMS Microbiol Lett
177:15-22
Gristina A (1987) Biomaterial-centered infection: microbial adhesion versus tissue integration. Science 237: 1588-1595
Gross M, Cramton SE, Gotz F, Peschel A (2001) Keyrole of teichoic acid net charge in Staphylococcus aureus colonization of artificial surfaces. Infect Immun 69: 3423-3426.
Gustilo RB, Merkow RL, Templeman D (1990) The management of open fractures. J Bone Joint Surg Am 72: 299-304.
Hanaki H, Labischinski H, Inaba Y, Kondo N, Murakami H, Hiramatsu K (1998) Increase in glutaminenon- amidated muropeptides in the peptidoglycan of vancomycin- resistant Staphylococcus aureus strain Mu50. J Antimicrob Chemother 42: 315-320.
Hartford OM, Francois P, Vaudaux P, Foster TJ (1997). The dipeptide repeat region of the fibrinogen-binding protein (clumping factor) is required for functional expression of the fibrinogen-binding domain on the Staphylococcus aureus cell surface. Mol Microbiol 25: 1065-7106
Hawiger JS, Timmons S, Strong DD, Cottrell BA, Riley M, Doolittle RF (1982) Identification of a region of human fibrinogen interacting with staphylococcal clumping factor. Biochem. 21: 1407-1413.
Heinrichs JH, Bayer MG, Cheung AL (1996) Characterisation of the sar locus and its interaction with agr in Staphylococcus aureus. J Bacteriol 178: 418-423.
Herrmann M, Lai QJ, Albrecht RM, Mosher DF, Proctor RA (1993) Adhesion of Staphylococcus aureus to surface- bound platelets: role of fibrinogen/ fibrin and platelet integrins. J Infect Dis 167: 312-322.
